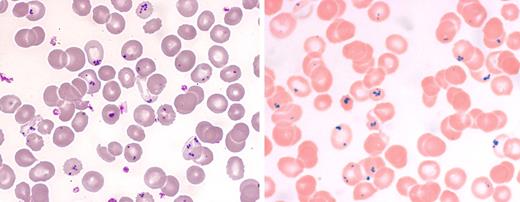
A 65-year-old woman with long-term alcohol abuse was admitted with fatigue, loss of appetite, and weight loss. Her past history included gastric surgery complicated by spleen rupture and subsequent splenectomy. Her physical examination was normal except for cachexia. She had a normocytic anemia (7.4 g/dL) with normal leukocyte and platelet counts, electrolyte abnormalities, and deficiencies of vitamins B1 and D. A blood smear showed red cell inclusions (left panel of figure) in approximately 20% of the erythrocytes. A Perls stain (right panel of figure) affirmed that the inclusions were iron positive (Pappenheimer bodies). While hospitalized, she was treated with optimal nutrition and vitamin B supplementation and was kept free of alcohol. One week later the fraction of erythrocytes with Pappenheimer bodies had decreased to 10%, and the patient was discharged soon after. / Dr A. M. Pappenheimer described the appearance of iron inclusions on the Wright stain. These iron inclusions had been previously noted on Prussian blue stains. Pappenheimer bodies are more evident in asplenic individuals; however, they may also be found in patients with alcohol excess, sideroblastic anemia, and lead poisoning. Other red cell inclusions, such as Howell Jolly bodies and Heinz bodies, which are also seen more frequently in asplenic individuals, are negative with iron stains.

A 65-year-old woman with long-term alcohol abuse was admitted with fatigue, loss of appetite, and weight loss. Her past history included gastric surgery complicated by spleen rupture and subsequent splenectomy. Her physical examination was normal except for cachexia. She had a normocytic anemia (7.4 g/dL) with normal leukocyte and platelet counts, electrolyte abnormalities, and deficiencies of vitamins B1 and D. A blood smear showed red cell inclusions (left panel of figure) in approximately 20% of the erythrocytes. A Perls stain (right panel of figure) affirmed that the inclusions were iron positive (Pappenheimer bodies). While hospitalized, she was treated with optimal nutrition and vitamin B supplementation and was kept free of alcohol. One week later the fraction of erythrocytes with Pappenheimer bodies had decreased to 10%, and the patient was discharged soon after.
Dr A. M. Pappenheimer described the appearance of iron inclusions on the Wright stain. These iron inclusions had been previously noted on Prussian blue stains. Pappenheimer bodies are more evident in asplenic individuals; however, they may also be found in patients with alcohol excess, sideroblastic anemia, and lead poisoning. Other red cell inclusions, such as Howell Jolly bodies and Heinz bodies, which are also seen more frequently in asplenic individuals, are negative with iron stains.
A 65-year-old woman with long-term alcohol abuse was admitted with fatigue, loss of appetite, and weight loss. Her past history included gastric surgery complicated by spleen rupture and subsequent splenectomy. Her physical examination was normal except for cachexia. She had a normocytic anemia (7.4 g/dL) with normal leukocyte and platelet counts, electrolyte abnormalities, and deficiencies of vitamins B1 and D. A blood smear showed red cell inclusions (left panel of figure) in approximately 20% of the erythrocytes. A Perls stain (right panel of figure) affirmed that the inclusions were iron positive (Pappenheimer bodies). While hospitalized, she was treated with optimal nutrition and vitamin B supplementation and was kept free of alcohol. One week later the fraction of erythrocytes with Pappenheimer bodies had decreased to 10%, and the patient was discharged soon after.
Dr A. M. Pappenheimer described the appearance of iron inclusions on the Wright stain. These iron inclusions had been previously noted on Prussian blue stains. Pappenheimer bodies are more evident in asplenic individuals; however, they may also be found in patients with alcohol excess, sideroblastic anemia, and lead poisoning. Other red cell inclusions, such as Howell Jolly bodies and Heinz bodies, which are also seen more frequently in asplenic individuals, are negative with iron stains.
For additional images, visit the ASH IMAGE BANK, a reference and teaching tool that is continually updated with new atlas and case study images. For more information visit http://imagebank.hematology.org.